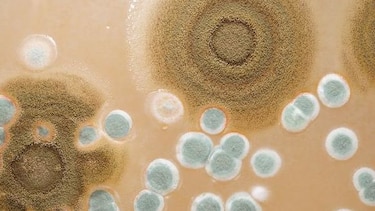
Estudios sobre hongo que afecta al tomate

Se calcula que hay aproximadamente 1.5 millones de especies de hongos en el mundo, de los cuales se han descrito o catalogado alrededor de 100 mil especies. Esta alta diversidad se atribuye a la diversidad morfológica de los hongos y a la variedad de hábitats. En Panamá, para 2013 se habían registrado unas 2 mil 400 especies.
Los hongos pueden ser aliados o enemigos. De las 100 mil especies catalogadas, el 90% son saprofitos; es decir, que se nutren de materia orgánica muerta. Sin embargo, hay unos pocos especializados que afectan a hospedantes específicos. Por ejemplo, se han encontrado unas 10 mil especies de hongos patógenos en plantas y unos 200 que son específicos de mamíferos. Para la ciencia, estudiar los hongos es importante en diversos ámbitos, como el de la salud humana y de los cultivos.
LABORATORIO
Muchos hongos desarrollan la capacidad de reconocer, invadir y penetrar a su hospedante específico, causándole una enfermedad. En el caso de las plantas, hongos del género Fusarium causan marchitez vascular en más de 100 especies reportadas de plantas de importancia agrícola, como el banano o plátano, el garbanzo, la planta de algodón y la de tomate, causando grandes pérdidas económicas.
La Dra. Gesabel Navarro, docente, investigadora y quien forma parte del programa de ampliación de la capacidad diagnóstica de plagas a través de la huella genética de ADN en la agricultura panameña, del Departamento de Vigilancia Fitosanitaria de la Dirección Nacional de Sanidad Vegetal del Ministerio de Desarrollo Agropecuario, ha estudiado el hongo Fusarium oxysporum, que afecta las plantas de tomate. Recientemente, compartió su experiencia en una charla dictada en el Instituto Smithsonian de Investigaciones Tropicales.
Navarro, quien hizo su tesis en la Universidad de Córdoba en España, explica que los hongos patógenos tienen un factor en común: son de crecimiento invasivo. Van penetrando los poros de las hojas y el Fusarium ataca la raíz directamente, en el caso del tomate. En España, Navarro y su equipo se concentraron en identificar nuevos componentes de una proteína llamada TOR en Fusarium oxysporum para determinar su papel en la patogénesis en plantas de tomate.
F. oxysporum es un hongo del suelo, donde puede estar largo tiempo como saprofito, esperando que aparezca su hospedante. También se puede transmitir por agua. Cuando la espora en el suelo detecta una planta específica, en este caso, el tomate, se generan esporas que invaden las raíces. Luego, el hongo avanza, colonizando el sistema vascular, llegando a las hojas y frutos. La planta se asfixia o no continúa con el transporte de agua y se marchita. Cae al suelo, y las esporas quedan esperando hasta que venga un nuevo hospedador.
Hongos del género Fusaryum también causan infecciones superficiales en la piel y córnea en personas con el sistema inmune comprometido, un problema que se agrava porque son resistentes a la mayoría de antifúngicos.
Navarro y sus colegas estudiaron la colonización de los tejidos de la planta de tomate por cepas silvestres y usando genes con mutaciones asociadas al crecimiento invasivo. También emplearon medios diferentes para comparar los nutrientes que favorecen o inhiben el crecimiento del hongo, y una prueba en la cual se usa celofán hecho de polímeros de celulosa, que se coloca en un plato petri con el medio de cultivo que se quiera investigar, para observar si el hongo penetra o no el celofán, que simula la superficie de la hoja. Hicieron, además, pruebas con el antibiótico rapamicina para evaluar la capacidad del hongo de crecer o ser inhibido; y usaron ratones y larvas de Galleria mellonella (polilla de la cera) como modelo animal.
Conocer cómo las mutaciones genéticas, los nutrientes disponibles o una proteína influyen en el crecimiento o virulencia del hongo en plantas y animales, puede dar luces sobre cómo disminuir los síntomas de enfermedad en caso de infecciones.